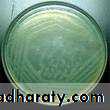
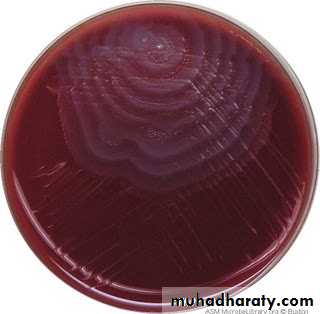
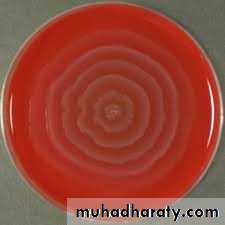
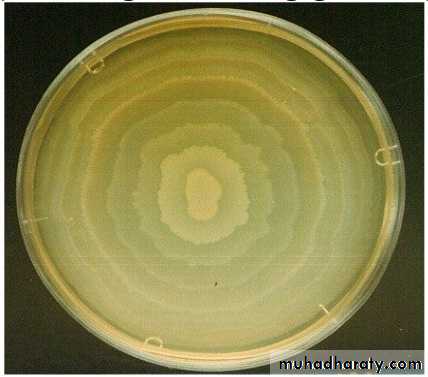
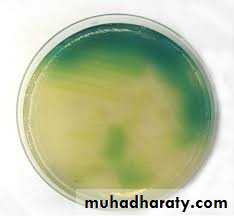
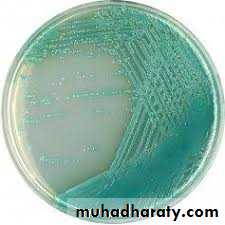
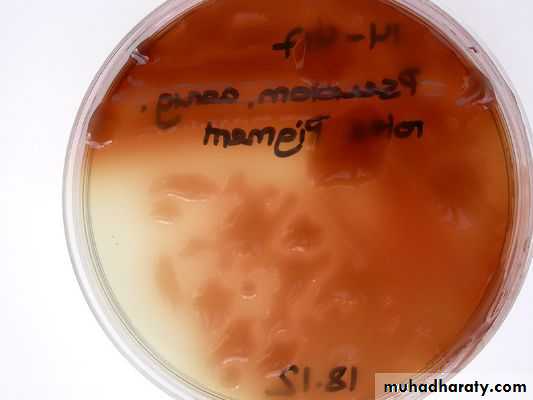
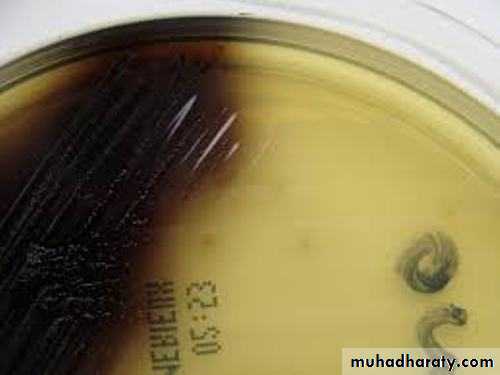
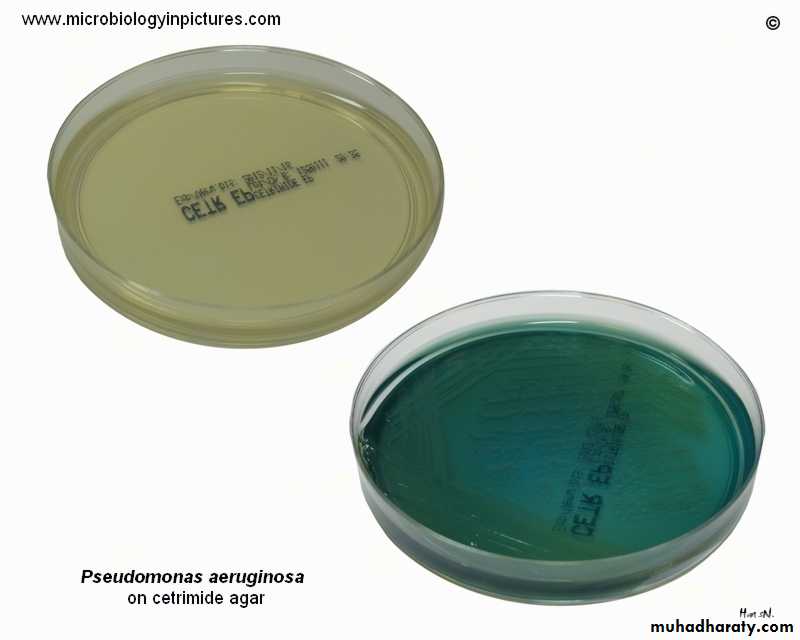

Genus ProteusGenus Pseudomonas
Mohammed Ameer
Genus ProteusMicroscopical appearance
Gram negative bacilli,pleomorphic.
Actively motile.
Non- capsulated.
Cultural characteristics
Grow on ordinary media.Swarming growth on non-inhibitory media.
Swarming is inhibited on MacConkey's agar & increase agar content.
Non lactose fermentor, transparent colonies.
Fishy smell.
H2S producer.
P. mirabilis K/A H2S+
P. vulgaris K/A Gas+ H2S+
Swarming growth
Biochemical reactions
1. IMViC Test : v+-v2. Urease test
Urea ammonia +CO2+ pH
Genus Proteus: +veurease
Phenylalanine phenyl pyruvic acid
Phenylalanine Agar
Addition of 10% ferric chloride(5 drops)
+ve Dark Green color on surface
of slant- ve No color change
Genus Proteus : +ve
3.Phenyl alanine deaminase test (Guthrie test)
phenyl alanine deaminaseincubation 24hrs.
Genus Pseudomonas
Gram negative bacilli
Actively Motile
Cultural characteristics
Aerobic2-4 mm, convex & opaque
Sweet musty odor, grape-like
Produce pigments :
• Fluorescein (yellow green).
• Pyocyanin (blue green).
• Pyorubin (dark red )
• Pyomelanin (dark brown)
Fluorescein
PyocyaninPyorubin
Pyomelanin
Cetrimide Agar
Cetrimide agar is a highly selective medium for pseudomonas species due to presences of cetrimide which inhibits the growth of other bacteria.
It contain also Mgcl2 & K2so4 to facilitate production the green pigment of pseudomonas.
Biochemical reactions
NLFUtilize glucose
Catalase test :+ve
Oxidase test :+ve
IMViC Test : - - - +
TSI: k (slant), K( butt)
Oxidation /Fermentation (O/F) Test
Principle:To determine the ability of bacteria to breakdown glucose oxidative or fermentive.
O/F medium (Hugh and Leifson Medium) is formulated to detect weak acids produced from saccharolytic M.O.
O/F medium contain:
Sugar (glucose 1%)
Low percentage of Agar and Pepton.
pH indicator (Bromothymol blue)
Alkaline Blue
Neutral Green
Acidic Yellow
Motility test
• A. Brownian movementB. True motility
1. Wet preparation
2. Hanging drop preparation
3. Semi solid medium